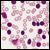

Researchers have characterized acute myeloid leukemia, providing new genetic driver leads to help classify the disease and even stratify AML patients by risk.

Your AI-Trained Oncology Knowledge Connection!



Researchers have characterized acute myeloid leukemia, providing new genetic driver leads to help classify the disease and even stratify AML patients by risk.

Multiple myeloma patients are at increased risk of developing myelodysplastic syndrome or acute leukemia after maintenance lenalidomide or thalidomide treatment, according to a new study.

A group of experts say that cancer drug prices, especially those for chronic myeloid leukemia, have skyrocketed, making patient treatment extremely difficult.

Targeting the bone marrow–specific extracellular matrix osteopontin may be an effective strategy to increase the efficacy of chemotherapy in patients with acute lymphocytic leukemia, according to the authors of a recent study.

A dose-adjusted regimen of etoposide, doxorubicin, and cyclophosphamide with vincristine, prednisone, and rituximab (DA-EPOCH-R) obviated the need for radiotherapy in patients with primary mediastinal B-cell lymphoma in a single-group, phase II, prospective study.

A study of patients with chronic myeloid leukemia treated with imatinib found that chronic fatigue is the major factor that limits health-related quality of life.

A majority of patients on imatinib for treatment of GIST or CML had low or absent levels of osteocalcin, a bone marker secreted by osteoblasts, and about 50% of patients had a decrease in bone mineral density, signaling that long-term treatment may affect bone health in these patients.

CML patients treated with nilotinib had fewer treatment-emergent BCR-ABL mutations than those treated with imatinib, and among patients who did have a mutation, those treated with nilotinib had reduced rates of progression to accelerated phase and blast phase of the disease.
Researchers have identified a novel monoclonal antibody directly targeted against a receptor found in abundance on chronic lymphocytic leukemia (CLL) cells, but not normal B cells. The humanized antibody can directly kill CLL cells.

Researchers have discovered a fully human “T-cell receptor–like” monoclonal antibody specific for the Wilms tumor 1 oncoprotein-an intracellular oncogenic transcription factor that is overexpressed in a wide range of leukemias, as well as solid cancers.

Combination chemotherapy with sequential administration of methotrexate and asparaginase was found to be effective salvage therapy in a small retrospective study of pediatric patients with relapsed or refractory acute myeloid leukemia (AML).

Contrary to previous laboratory findings, a new study has shown for the first time the effect of stem cell burden on treatment outcome, discovering that tyrosine kinase inhibitors, including imatinib and dasatinib, can rapidly eradicate most chronic myeloid leukemia stem cells.

The European Medicines Agency adopted a “positive opinion” earlier this year regarding conditional marketing approval for bosutinib for the treatment of Philadelphia chromosome-positive chronic myeloid leukemia.

Findings of a newly published study by an international team of researchers suggest that targeting growth factor independence 1 (GFI1) may improve the prognosis of patients with T-cell acute lymphoblastic leukemia or other lymphoid leukemias.

Researchers from the University of Rochester have identified BCL2 inhibitors as potential leukemia stem cell-targeting agents, demonstrating that two such inhibitors killed inactive and metabolically slower leukemia stem cells.

New research suggests that a novel, investigative drug could help alleviate some of the resistance to tyrosine kinase inhibitor treatment seen in chronic myeloid leukemia (CML). The drug, a pan-BCL2 inhibitor called sabutoclax, could sensitize malignant leukemic stem cells in the bone marrow niche to TKI treatment.

As patients and physicians gain experience with a second generation of relatively effective therapies for chronic myeloid leukemia, there is increasing need to quickly understand who will fare best with these drugs.

Elderly patients may have several such comorbidities, but their impact on normal life is minimal-and so most of these patients may receive a curative treatment such as R-CHOP. Very elderly patients have more comorbidities with greater impact, with the result that some of their vital organs exhibit functional deficiency.

In this review, we critically analyze clinical trials that were specifically designed for the very elderly, and we discuss the challenges encountered by investigators who are conducting studies in this patient population. We conclude by proposing an algorithm to help clinicians determine the optimal therapeutic strategy for treatment of DLBCL in very elderly patients.

It is hard to realize that an elderly patient's visit to you is likely the only trip outside his or her apartment for the week and the only contact with someone other than family or an aide. Doctor visits sometimes become the elderly's primary contact with the larger world.

The US Food and Drug Administration has approved imatinib (Gleevec) for the treatment of newly diagnosed Philadelphia chromosome–positive acute lymphoblastic leukemia (Ph+ ALL) in children.

A single tube 10-color assay for the detection of residual disease in chronic lymphocytic leukemia provides at least equivalent results to the international standardized flow cytometry approach to detection and requires fewer cells, uses fewer reagents, and allows for simpler analysis, according to a new study.

The combination of two antibody-based targeting agents-inotuzumab ozogamicin and rituximab-demonstrated high response rates and long progression-free survival in patients with relapsed follicular lymphoma or relapsed diffuse large-B-cell lymphoma (DLBCL) in an international phase I/II multicenter, open-label study.

Researchers have identified an enzyme that plays an important role in the reprogramming of malignant progenitor cells in chronic myeloid leukemia. The enzyme, ADAR1, could represent a target for selecting and eradicating leukemia stem cells.

In this interview we discuss the latest chronic myeloid leukemia treatment and research with Dr. Michael Deininger, chief of the division of hematology at the University of Utah School of Medicine.